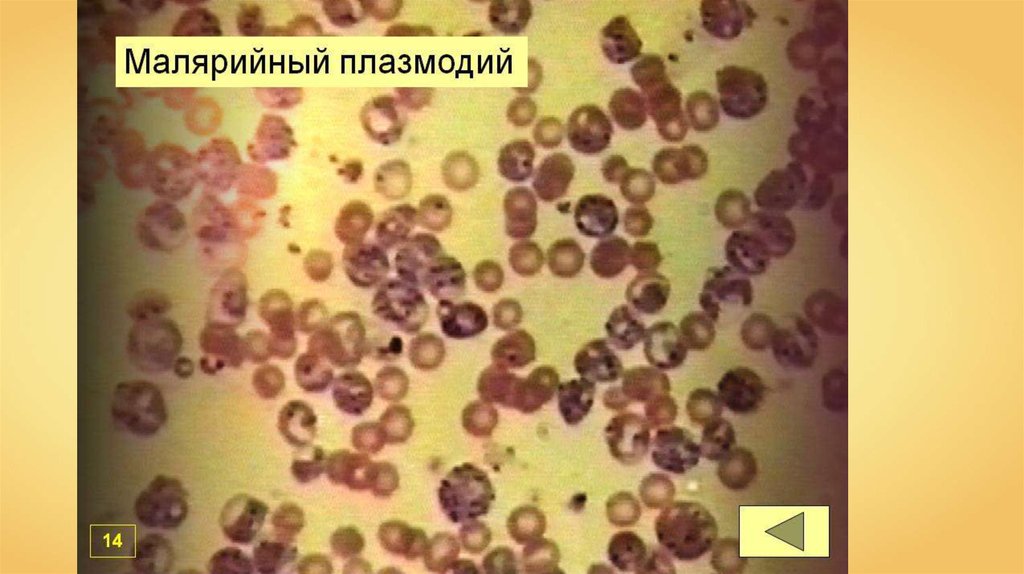

Similar presentations:
Подцарство одноклеточные. Тип инфузории
1.
Передвижение простейших2.
Передвижение инфузорийMicropix
Инфузория-туфелька
Трубач
Simon Andrews
Сувойка
3.
Тип Инфузории (Ciliophora)4.
Инфузории-паразитыДегенерация —
упрощение строения
организма в ходе эволюции.
5.
Строение Инфузории-туфелькиЯдра
Сократительные
вакуоли
Порошица
6.
Строение Инфузории-туфелькиМакронуклеус
отвечает за питание,
дыхание, передвижение,
обмен веществ.
Микронуклеус
участвует в половом
размножение
7.
Строение Инфузории-туфелькиПелликула
8.
Строение Инфузории-туфелькиРеснички
9.
Строение ресничекБазальное тельце
Franciscosp2
10.
Строение Инфузории-туфелькиРот (цитостом)
Глотка
(цитофаринкс)
Пищеварительная
вакуоль
Порошица
11.
Строение Инфузории-туфелькиСократительные
вакуоли
Радиальные
канальцы
12.
Дыхание Инфузории-туфелькиО2
О2
О2
О2
О2
О2
О2
О2
13.
Бесполое размножениеTheAlphaWolf
14.
Половое размножениеОбразование
цитоплазматического мостика
Микронуклеусы
делятся на 4 дочерних клетки
15.
Половое размножениеМитоз —
образование двух ядер
Перемещение
мужских ядер
16.
Половое размножениеСлияние
мужского и женского ядра
Синкарион
Обмен
генетической информацией
17.
Половое размножениеПроцесс митоза
18.
Половое размножениеМикронуклеус
Макронуклеус
Старый
макронуклеус
19.
Половое размножениеМикронуклеус
Макронуклеус
20.
Многообразие инфузорий7 тысяч видов
Различные сферы
жизни
Jurijs
Бурсария
Simon Andrews
Сувойка
Euthman
Балантидия
Инфузории — наиболее организованные
Простейшие.

biology
biology








